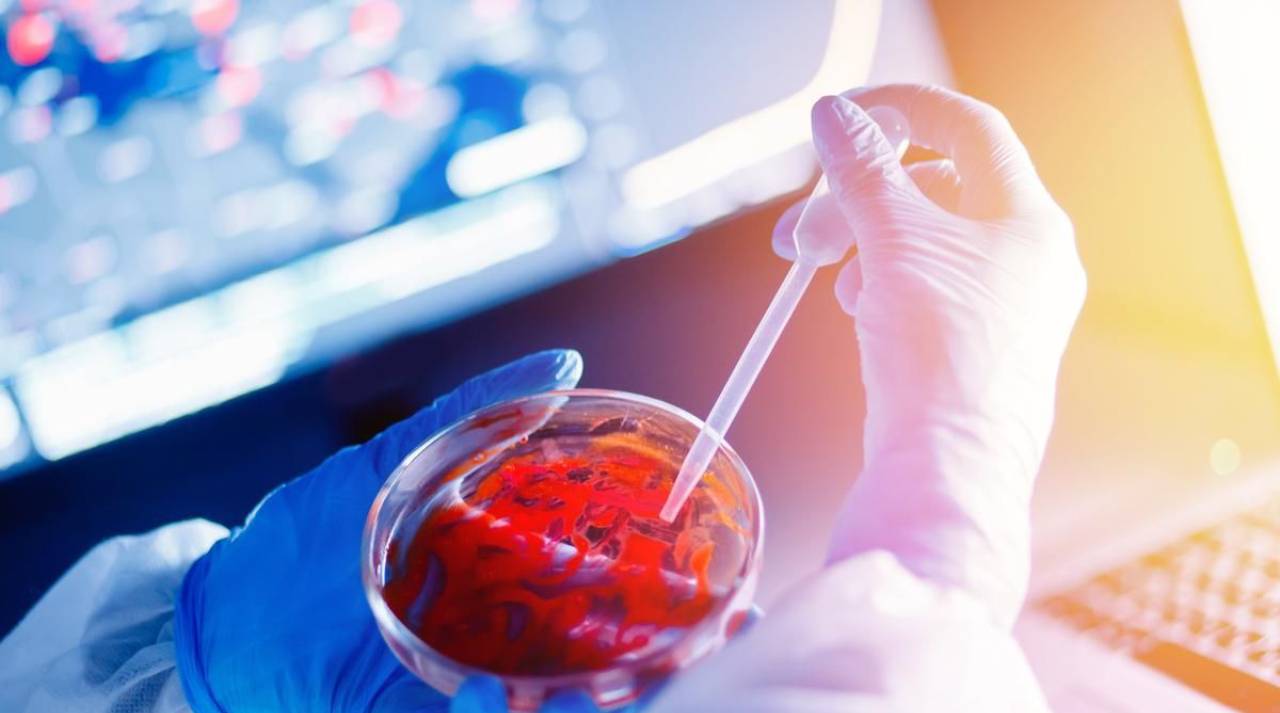

Tháng 1, 2025
- 15 Tháng 1
Chuyên gia cảnh báo: Úc đề phòng sự bùng phát trở lại của ‘Cái chết đen’
Cái Chết Đen, còn được gọi là bệnh dịch hạch chuột, đã từng lan rộng nhanh chóng ở châu Âu vào thế kỷ 14.
Tháng 3, 2020
- 12 Tháng 3
“Cảm ơn” ôn dịch đã giúp thế giới nhìn rõ bộ mặt thật của ĐCSTQ
Thế giới nên cảm ơn ôn dịch đã giúp nhìn rõ bộ mặt thật của ĐCSTQ. Bài viết thể hiện quan điểm của ông Hồng Bác Học, độc quyền đăng trên Vision Times.